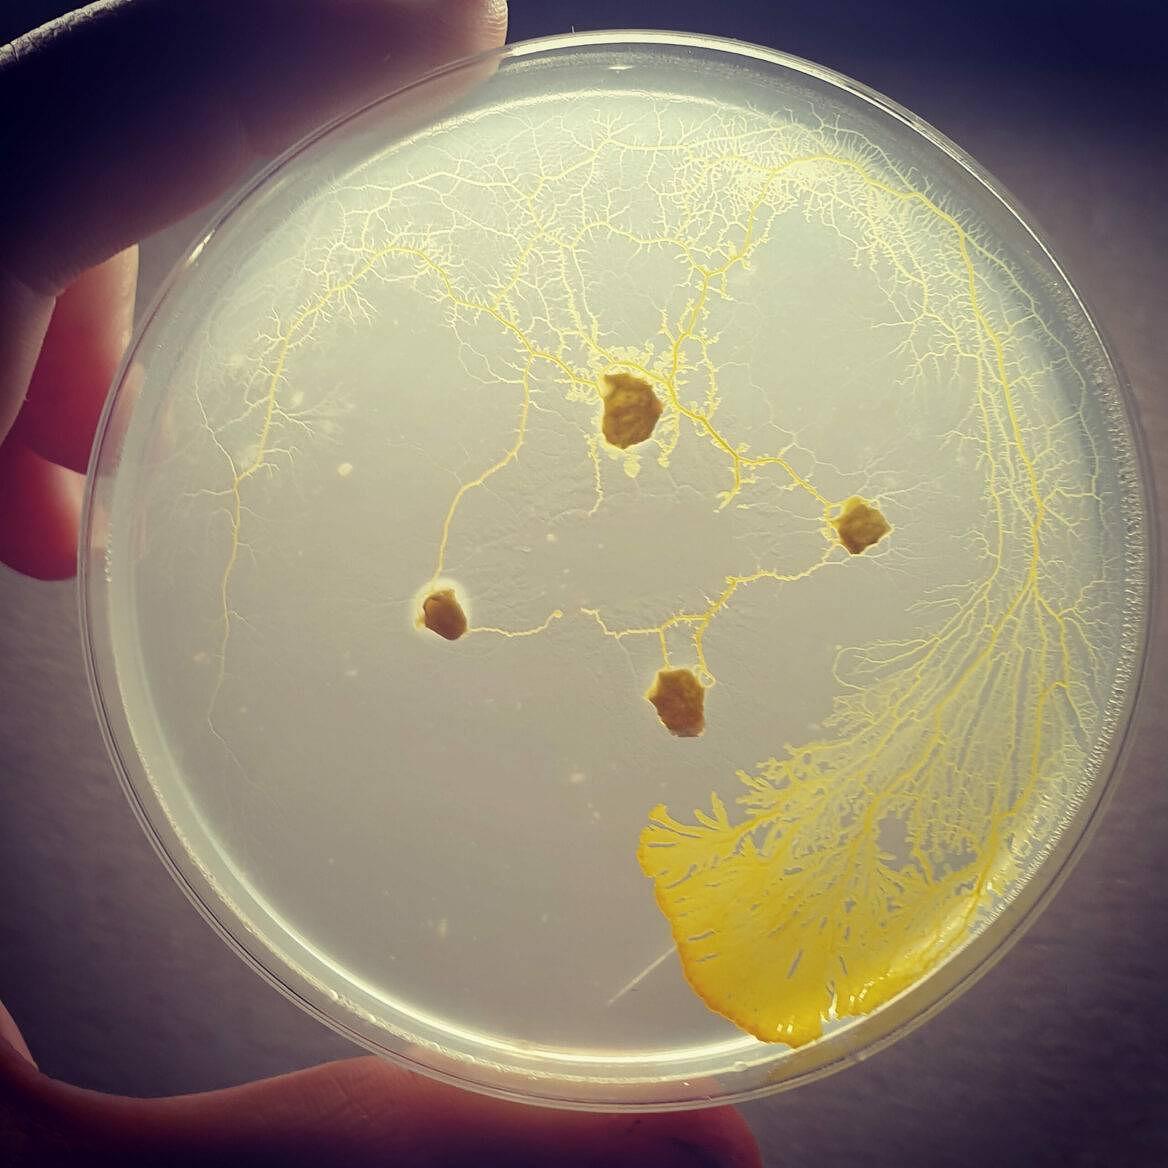

Stage enfants "Le labo du blob"
Inscrivez dès maintenant votre enfant pour le stage de juillet !
Du 8 au 12 juillet 2024, les enfants de 7 à 12 ans se mettront dans la peau de chercheurs en biologie et observeront un blob. Les enfants présenteront un poster scientifique, imaginé durant la semaine.

C’est quoi un blob ?
Le blob est un organisme qui ressemble à un champignon mais qui n’est ni un champignon, ni un animal et encore moins un végétal. C’est un myxomycète !
Il n’est composé que d’une seule cellule. Il est extrêmement étonnant car il est très intelligent et capable de résoudre des problèmes et des labyrinthes.
L’objectif du stage

Le stage « Le labo du Blob » est une super occasion pour les enfants d’enfiler la blouse d’un chercheur en biologie !
Ils créeront un protocole de recherche en rapport avec le blob et imagineront un poster scientifique afin de le présenter dans un congrès scientifique.
Le déroulé de la semaine

Inscriptions
Vous pouvez inscrire votre enfant dès maintenant et jusqu’au 1 juillet.
